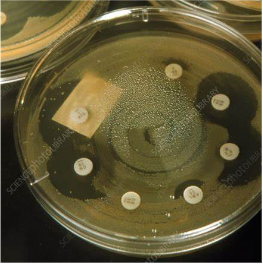

Navigating Urinary Tract Infections (UTIs): Understanding, Diagnosis, and Prevention
Introduction
Urinary Tract Infections (UTIs) can be uncomfortable and inconvenient, but understanding their symptoms, diagnosis, and prevention strategies can empower individuals to take control of their urinary health. In this post, we will delve into the common signs of UTIs, demystify medical terminology, discuss the epidemiology of UTIs, explore the diagnosis process, and provide practical tips for prevention.
Understanding UTI Symptoms:
Do you experience a burning sensation or pain during urination? Feel pressure in the lower abdomen radiating to the back? Constantly feel the urge to go or like you can't completely empty your bladder? These could be signs of a UTI.
Terminology Demystified:
UTIs encompass infections in any part of the urinary tract, from the urethra to the kidneys. They are categorized into simple cystitis (confined to the bladder) and complicated UTIs (potentially involving kidneys). For this discussion, we'll focus on simple cystitis, the most common type.
Epidemiology
UTIs among females are extremely common. They are more common in females due to the short urethra length as seen in the picture, allowing for an easier pathway for bacteria to enter. Risk factors can include recent sexual intercourse, contact with foreign objects (i.e. condoms, diaphragms, toys, etc), diabetes, as well as those with previous history of UTI.
Diagnosis and Testing
The tricky part about UTIs is early diagnosis and treatment to prevent the bacteria from ascending to the kidneys potentially causing a more systemic and serious illness. Because of the potential harmful implications for waiting for definitive diagnosis, we as doctors, are usually inclined to treat them “empirically.” This means to treat it based on clinical judgment and experience, rather than wait on more specific diagnostics tests.
After hearing about your symptoms your doctor may want to perform a dipstick urinalysis (done easily in the office). This will tell us on a roughly 1-3 scale of different types of contents in your urine (i.e. red blood cells, white blood cells, nitrites). Using this data along with your symptoms, the doctor can make a judgment call on whether or not to start empiric treatment for a UTI. If empirical treatment is initiated, antibiotics are prescribed.
Culture and Sensitivities (IMPORTANT)
This is perhaps the most important, and poorly understood part of the entire process. After the dipstick in the office is performed, the rest of your urine is then usually sent to a lab for further analysis. Here they will put some of your urine on a petri dish and grow out the bacteria. This takes days, as they literally need to grow the bacteria. Afterwards, they will identify the bacteria microscopically and test out what antibiotics work to kill the bacteria as seen in the picture. The picture shows a petri dish with the yellow discoloration being bacteria. As you can see the bacteria is sensitive (clear areas) to certain antibiotics while resistant (non cleared areas) to others. You can also see that different antibiotics are more powerful at killing the bacteria than others by the larger cleared area. These will then be reported back as sensitivities to your doctor. It is absolutely imperative that you and your doctor follow up the results. This can result in non-treatment or incomplete treatment of your UTI. This can be scary as sometimes you may feel better, as most of the bacteria was killed, but substantial surviving bacteria may remain causing ascending complicated UTIs that could be life threatening. This little known fact is very important, probably the most important of this whole article.
UTI prevention
UTI prevention can be thought of in two ways, preventing bacteria from getting in and preventing it from growing.
To prevent bacteria from getting in, you can: wear comfortable breathable cotton underwear, avoid tight clothing which can be a vector for bacteria, Include good hygienic practices like wiping from front to back. Avoid soaking in dirty water or using strong scented soaps which may irritate our bodies natural defenses and allow bacteria to enter.
Once bacteria does enter, it also helps to prevent it from growing. Think of this much like a river. If the river stops flowing and forms a swamp type situation, bacteria is more likely to thrive. You can help this by staying hydrated and emptying your bladder regularly. This may also be practiced right after sexual intercourse, to help prevent foreign bacteria from growing.
As always it is important to boost your immune system with diet and exercise, and some studies show the possibility that probiotics may help.
Summary
If you experience vague lower abdominal urinary symptoms, consult a doctor for early intervention. Empirical treatment may be initiated based on clinical judgment. Always follow up on sensitivity results, stay hydrated, and practice good hygiene to prevent UTIs. Taking proactive steps can lead to better urinary health and well-being.